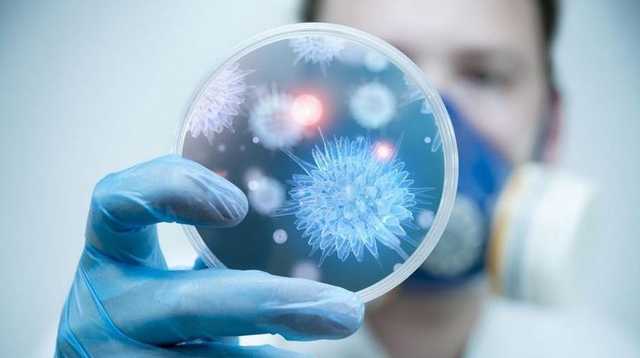
В Украине еще один человек умер от гриппа

В Украине еще один человек умер от гриппа
В Украине еще один человек умер от гриппа
Как сообщили в Центр общественного здоровья министерства здравоохранения Украины, в этом эпидемическом сезоне еще один, 48-ой по счету, человек умер из-за вируса в течение 11 недели текущего года (11-17 марта).
Как отмечается, среди погибших также семеро детей в возрасте до 17 лет, однако никто из погибших не вакцинировался против вируса.
В то же время заболеваемость гриппом и ОРВИ в стране идет на спад – количество инфицированных взрослых снизилось на 2,6%, однако детей до 17 лет – увеличилось на 0,3%.
“Интенсивный показатель заболеваемости составил 398,3 на 100 000 населения, что на 23,2% меньше эпидемического порога по Украине”, – констатируют в Минздраве.
В то же время заболеваемость гриппом и ОРВИ в стране идет на спад – количество инфицированных взрослых снизилось на 2,6%, однако детей до 17 лет – увеличилось на 0,3%.
“Интенсивный показатель заболеваемости составил 398,3 на 100 000 населения, что на 23,2% меньше эпидемического порога по Украине”, – констатируют в Минздраве.
Теги: ОРВИМинздрав УкраиныБолезниЖертвыГрипп

Комментарии:
comments powered by DisqusЗагрузка...
Наши опросы
Показать результаты опроса
Показать все опросы на сайте











